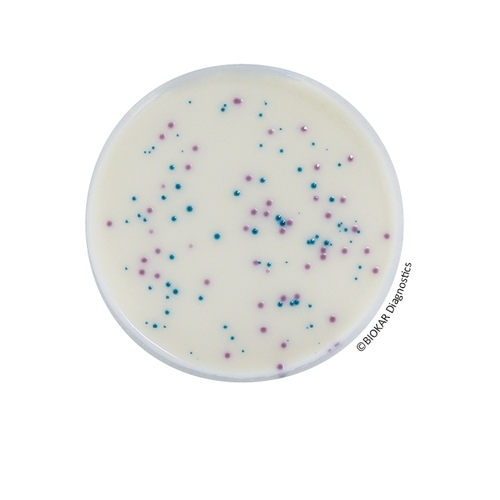
IRIS Salmonella®

IRIS Salmonella®
IRIS Salmonella® is an alternative research method of Salmonellae in human food and feeds, and environmental sample (except primary production samples). Studies performed on IRIS Salmonella® Agar show a high specificity for the detection of Salmonellae including atypical species and serovars, which is a source of confusion on other medium. Indeed, the detection of Salmonella Typhi and Paratyphi, lactose-positive Salmonellae (Salmonella Senftenberg and subspecies S. arizonae and S. diarizonae), saccharose-positive strains are ensured. The media allows the detection of non-motile serovars (S. Pullorum and S. Gallinarum) or monophasic strains. IRIS Salmonella® Agar allows also the detection of strains which show a light or absence of esterasic activity on other medium (Salmonella bongori, Salmonella Dublin and Atento, certain strains of S. enterica, S. houtenae and S. diarizonae subspecies). IRIS Salmonella® method is officially certified by AFNOR Certification, under the reference number BKR 23/07-10/11, for all human and animal food products and production and production environment samples (excluding primary production environment samples).IRIS Salmonella® is also validated for the detection of Salmonellae in samples from 50 g to 375 g for milk powder, including infant milk with and without probiotics and from 50 g to 125 g for flours and croquettes in animal feedstuffs.
| Ürün Adı | IRIS Salmonella® Supplement - Tablets qsq 90 ml |
| Ürün Kodu | BS09308 |
| Miktar | 120 tablets qsp 90 mL |
| Ürün Adı | IRIS Salmonella® - Latex agglutination kit |
| Ürün Kodu | BT01108 |
| Miktar | Kit of 50 Test |
| Açıklama | Kit of Latex agglutination test: |
| Ürün Adı | IRIS Salmonella® Supplement liquid |
| Ürün Kodu | BS07808 |
| Miktar | 10 vials of 50 mL |
| Ürün Adı | IRIS Salmonella® Supplement - Tablets |
| Ürün Kodu | BS07708 |
| Miktar | 120 tablets qsp 225 mL |
| Ürün Adı | IRIS Salmonella® |
| Ürün Kodu | BM14408 |
| Miktar | 2 flexible bags of 5 L |
| Ürün Adı | IRIS Salmonella® |
| Ürün Kodu | BM16308 |
| Miktar | 3 flexible bags of 3 L |
| Ürün Adı | IRIS Salmonella® |
| Ürün Kodu | BM13708 |
| Miktar | 3 flexible bags of 3 L |
| Ürün Adı | IRIS Salmonella® |
| Ürün Kodu | BM13608 |
| Miktar | 10 vials of 225 mL |
| Ürün Adı | IRIS Salmonella® |
| Ürün Kodu | BM16008 |
| Miktar | 20 Petri plates Ø 90 mm |
| Ürün Adı | IRIS Salmonella® |
| Ürün Kodu | BM16108 |
| Miktar | 120 Petri plates Ø 90 mm |
TECHNICAL DATA SHEET
TDS_IRIS SALMONELLA_BM160_161_BS077_078_ENv4
MSDS
Non classification statement_BM160_161
FDS_MSDS_BK212_v1
Non classification statement_BM136_137_144
Non classification statement_BM163
Non classification statement_BK194
FDS_MSDS_BS077_v2
FDS_MSDS_BS078_v1
FDS_MSDS_BS093_v2
Non classification statement_BT011_R1_R2